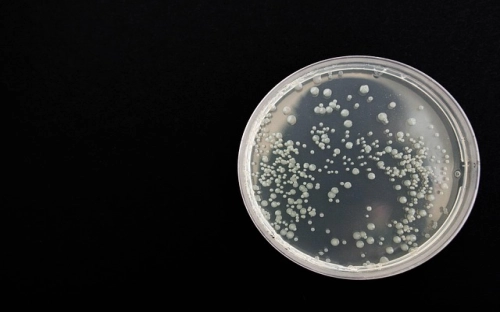
生物实验报告《观察植物细胞的有丝分裂》-春林公文网

2021建筑工程质量管理工作汇报范文
建筑工程的质量十分重要,若出现问题,将造成重大事故。下面是小编整理的建筑工程质量管理工作汇报范文,希望对大家有帮助。 建筑工程质量管理工作汇报1 ____项目自20____年4月1日正式开工,至...
基层党建调研报告
为切实加强农村党组织建设,进一步研究和解决新形势下农村党建工作存在的问题,全面把握农村基层组织建设情况,为开展好农村基层组织建设年活动活动打好基础。 一、基层党组织的基本概况 党委下...
学习科学发展观心得体会:在深入学习上再下功夫
把学习贯穿始终,是开展学习实践科学发展观活动的一项基本要求。目前,第一批学习实践活动学习调研阶段在不少单位即将结束,但是学习仍要抓紧,不能放松。学习实践活动要在提高认识、统一思想、...
精选社会调查报告模板集合7篇
精选社会调查报告模板集合7篇 在生活中,报告的使用频率呈上升趋势,报告成为了一种新兴产业。那么你真正懂得怎么写好报告吗?以下是小编精心整理的社会调查报告7篇,欢迎大家借鉴与参考,希望...
民宗局局长述职述廉报告范文,述职述廉
民宗局局长述职述廉报告 根据组织工作安排,我在上半年主要协助政府分管领导抓畜牧业工作,下半年担任县民宗局局长主要抓全县民族宗教事务工作。一年来,在县委、县政府的正确领导和同志们...
最新公司注销申请报告格式例文三篇参阅
公司注销作为公司解散、清算的后续步骤,是对公司主体法人资格消灭的确认。接下来范文库范文网为大家准备了最新公司注销申请报告格式例文三篇参阅,希望能对您有帮助。 篇一: 受 理 号: 受理日...
个人整改方案2
一、指导思想以马列主义、毛泽东思想、邓小平理论和'三个代表'重要思想为指导,以保持共产党员先进性教育活动为契机,以党章要求和'十好党员'标准为尺子,以自我剖析材料为依据,认真学习'三个...
市外经贸局帮扶社区工作情况汇报
市外经贸局帮扶社区工作情况汇报 三年来,我局认真贯彻《中国共产党景德镇市委关于建立市直单位与社区居委会结对共建的实施意见》(景字[2005]1号文件精神,按照努力建设“居民自治,管理科学,...
中学语文实习报告范文
中学语文实习报告范文1 一、实习概况在电大学习即将结束之际,学校为了检验我们对所学知识的运用能力,加强理论与实践的结合,进一步激发我们对教育事业的责任感,增强语文教学的能力,促进我们...
林业局先进性教育活动整改提高阶段小结
保持共产党员先进性教育活动转入整改提高阶段以来,我们紧密结合部门实际,从广大群众和林果农最不满意的地方改起,围绕实现好、发展好、维护好群众和林果农的根本利益去想问题、做工作,扎扎实...
农业项目验收报告范文精选三篇
验收报告是指工程项目完工之后,通过相关部门建立的特意验收机构,组织专家进行质量评估验收以后形成的书面报告。以下是范文库小编整理的项目验收报告,供大家参考借鉴,希望可以帮助到有需要的...
后勤专员述职报告
后勤专员述职报告范文(精选6篇)在我们无暇顾及时间时,时间早已匆匆流逝,你梳理过这段时间的工作吗?是时候静下心来好好写写述职报告了。我们该怎么去写述职报告呢?下面是小编整理的后勤专...
中学生手机消费调查报告
中学生手机消费调查报告 随着生活水平的改善,手机的普及率开始升高,且使用者范围也开始扩张,还记得前几年,拥有一部属于自己的手机,是一件很了不起的事。但是20世纪的今天,却不同了,在学...
个人自查报告
【精华】个人自查报告模板六篇 随着个人素质的提升,我们都不可避免地要接触到报告,报告具有双向沟通性的特点。相信许多人会觉得报告很难写吧,以下是小编精心整理的个人自查报告7篇,供大家参...
环境心理学调研报告
调研内容: 西单商业区算是人们最爱去也是最常去的商业去了,主要的原因就是这里的东西适合各个年龄层和消费层,位于西单大街西侧的大悦城,君太百货和位于西单大街东侧的中友百货就很适合各个...
【精选】实习周记汇编10篇
【精选】实习周记汇编10篇 时间真是转瞬即逝,一周又过去了,这一周里,大家都有不少感想吧,是时候静下心来好好写写周记了。可是怎样写周记才能出彩呢?下面是小编收集整理的实习周记10篇,仅...
精选暑假实习报告范文8篇
精选暑假实习报告范文8篇 在经济发展迅速的今天,接触并使用报告的人越来越多,不同种类的报告具有不同的用途。为了让您不再为写报告头疼,下面是小编整理的暑假实习报告8篇,希望对大家有所帮...
大学生社会实践调查报告
大学生社会实践调查报告 调查目的:时下,大学生通过利用课余时间找份兼职工作打打工或在假期积极参与社会实践,打暑期工、实习体味生活已经成为了一股热潮。对大多数学生而言,挣钱是打工的首...
检察院民主生活会自我剖析及整改措施
检察院民主生活会自我剖析及整改措施 在开展“强化法律监督、维护公平正义”和“两个务必”教育活动中,我坚持以党的十六大精神为指导,认真学习领会和深入贯彻落实胡锦涛同志在西柏坡考察时的...
生物实验报告《观察植物细胞的有丝分裂》
一、实验目的 1.观察植物细胞有丝分裂的过程,识别有丝分裂的不同时期。 2.初步掌握制作洋葱根尖有丝分裂装片的技能。 3.初步掌握绘制生物图的方法。 二、实验原理 在植物体中,有丝分裂常见于...